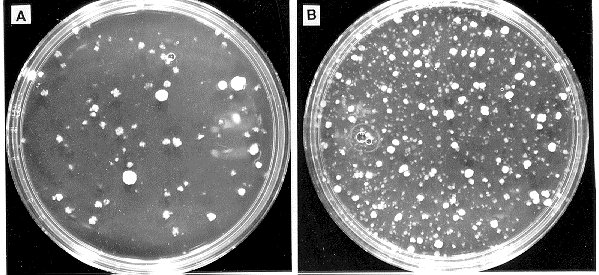

Transformation of N. crassa using the calcium chloride/polyethylene glycol procedure (Fincham 1989. Microbiol. Rev. 53:148-170) can yield 100-10,000 transformants per microgram of input DNA when integration occurs nonhomologously, and considerably lower numbers of transformants when homologous integration of DNA is required. Increasing the efficiency of transformation would be useful for screening cosmid libraries and for obtaining transformants from homologous integration events. In addition, strains that transform poorly using standard procedures, e.g. the cell-wall-less derivatives of os-1 (Phelps et al. 1990 Curr. Microbiol. 21:233-242) would benefit from improvements in the transformation procedure. Lipofectin, a liposome preparation formulated from cationic lipids [Bethesda Research Laboratories, Gaithersburg, MD], has been reported to increase transformation of the yeast Schizosaccharomyces pombe by 35-fold with plasmids or large (>500 kb) linear DNA molecules (Allshire 1990 Proc. Natl. Acad. Sci. USA 87:4043-4047). In an effort to increase the transformation efficiency of N. crassa, we tested the effects of including lipofectin in a standard transformation procedure.
Germinated macroconidia of wild type N. crassa (74-OR23-1VA) were grown, harvested and counted. Protoplasts were obtained by treatment with Novozym 234 as described (Orbach et al. 1986 Mol. Cell. Biol. 6:2452-2461). Protoplasts of the os-1 derivative TM-1 were grown and harvested as described (Phelps et al. 1990 Curr. Microbiol. 21:233-242). Protoplasts of both strains were washed twice with 1 M sorbitol and once with STC (1 M sorbitol, 50 mM Tris-HCl pH 8.0, 50 mM CaCl2). Protoplasts were resuspended in STC (0.4 ml per 5 x 10(7) cells). Then 0.1 ml PTC (40% polyethylene glycol 3300 [Sigma Chemical Co., St. Louis, MO], 50 mM Tris-HCl pH 8.0, 50 mM CaCl2) and 5 ul of dimethyl sulfoxide were added per 5 x 10(7) cells. Competent protoplasts were stored at -80 C after aliquoting into eppendorf tubes; aliquots in tubes were transferred directly from wet ice to the -80 C freezer.
For transformation, cells were thawed on ice. DNA was premixed with heparin (25 ul; 125 ug) in 12 x 75 mm polystyrene tubes [Falcon 2058 tubes; Becton Dickinson Labware, Lincoln Park, NJ]; cells (0.1 ml) were added and the mixtures incubated on ice for 30 min. Lipofectin was added, and incubation continued for 15 min at room temperature. One ml of PTC was added, and after gentle mixing, suspensions were incubated 20 min at room temperature. Aliquots were added to molten regeneration agar overlayed on minimal plates containing 1 ug/ml benomyl (DuPont, Wilmington, DE) or 200 ug/ml Hygromycin B (Boehringer Mannheim, Indianapolis, IN). Plates were scored after 48 h incubation at 34 C (for wild type) or after 96 h at 25 C (for TM1).
Inclusion of lipofectin at a concentration of 35 ug per ml of wild type protoplasts in the standard protocol increased yields of transformants by nearly 10-fold (Fig. 1) when expression of a semi-dominant allele of the tub-2 gene (Orbach et al. 1986 Mol. Cell. Biol. 6:2452-2461), which confers benomyl resistance, was selected. Lipofectin at concentrations higher than 50 ug/ml did not result in increases in transformation (not shown). Similar results were obtained using a library of cosmid DNA to transform N. crassa to hygromycin resistance (Fig. 2). The efficiency of transformation of TM-1 protoplasts to benomyl or hygromycin resistance, using pMO63 or pMOcosX cosmid library DNA, respectively, increased 3-4 fold (average of 4 transformations) when lipofectin was included in the transformation procedure (data not shown). Addition of PTC appeared necessary for efficient transformation of N. crassa with or without added lipofectin; preincubation of DNA with lipofectin prior to addition of spheroplasts did not increase transformation efficiency compared to controls lacking lipofectin. We have limited results concerning the stability of recovered transformants in that 15/15 colonies recovered from primary transformation plates were stable (i.e., grew on hygromycin-containing medium for at least two transfers.
Our results show that addition of lipofectin to a standard N. crassa transformation protocol increases the number of recovered transformant colonies 3-10 fold. These increases should prove helpful for experiments in which the highest possible transformation efficiencies are desired.
Acknowledgements: We thank Dr. N. Raju for processing Fig. 2. CPS thanks Dr. David Perkins and Dr. Charles Yanofsky for their gracious hospitality while on sabbatical leave at Stanford University. MSS thanks Dr. Yanofsky for helping to support his postdoctoral study. This work was supported in part by NIH and NSF grants to CPS.

Figure 1: Effects of lipofectin concentration on transformation of wild type N. crassa with
a plasmid conferring benomyl resistance. Wild type protoplasts were incubated with 2 ug
(open symbols) or 5 ug (closed symbols) of pMO63 DNA and 0, 15, 35, or 50 ug/ml of
lipofectin. The number of benomyl-resistant colonies obtained per microgram of DNA at
each lipofectin concentration is plotted as a function of lipofectin concentration. pMO63
contains the mutant tub-2 gene that confers benomyl resistance on a 3.1 kb HindIII
fragment.
Figure 2: Lipofectin increases the efficiency of transformation of N. crassa to hygromycin resistance with cosmid
DNA. Wild type protoplasts (0.1 ml) were incubated with 1 ug of pooled cosmid DNA in vector pMOcosX and
(A) no lipofectin or (B) 35 ug/ml lipofectin. One-tenth of the transformation mixture was plated on each plate.
The pMOcosX library is available through the FGSC.